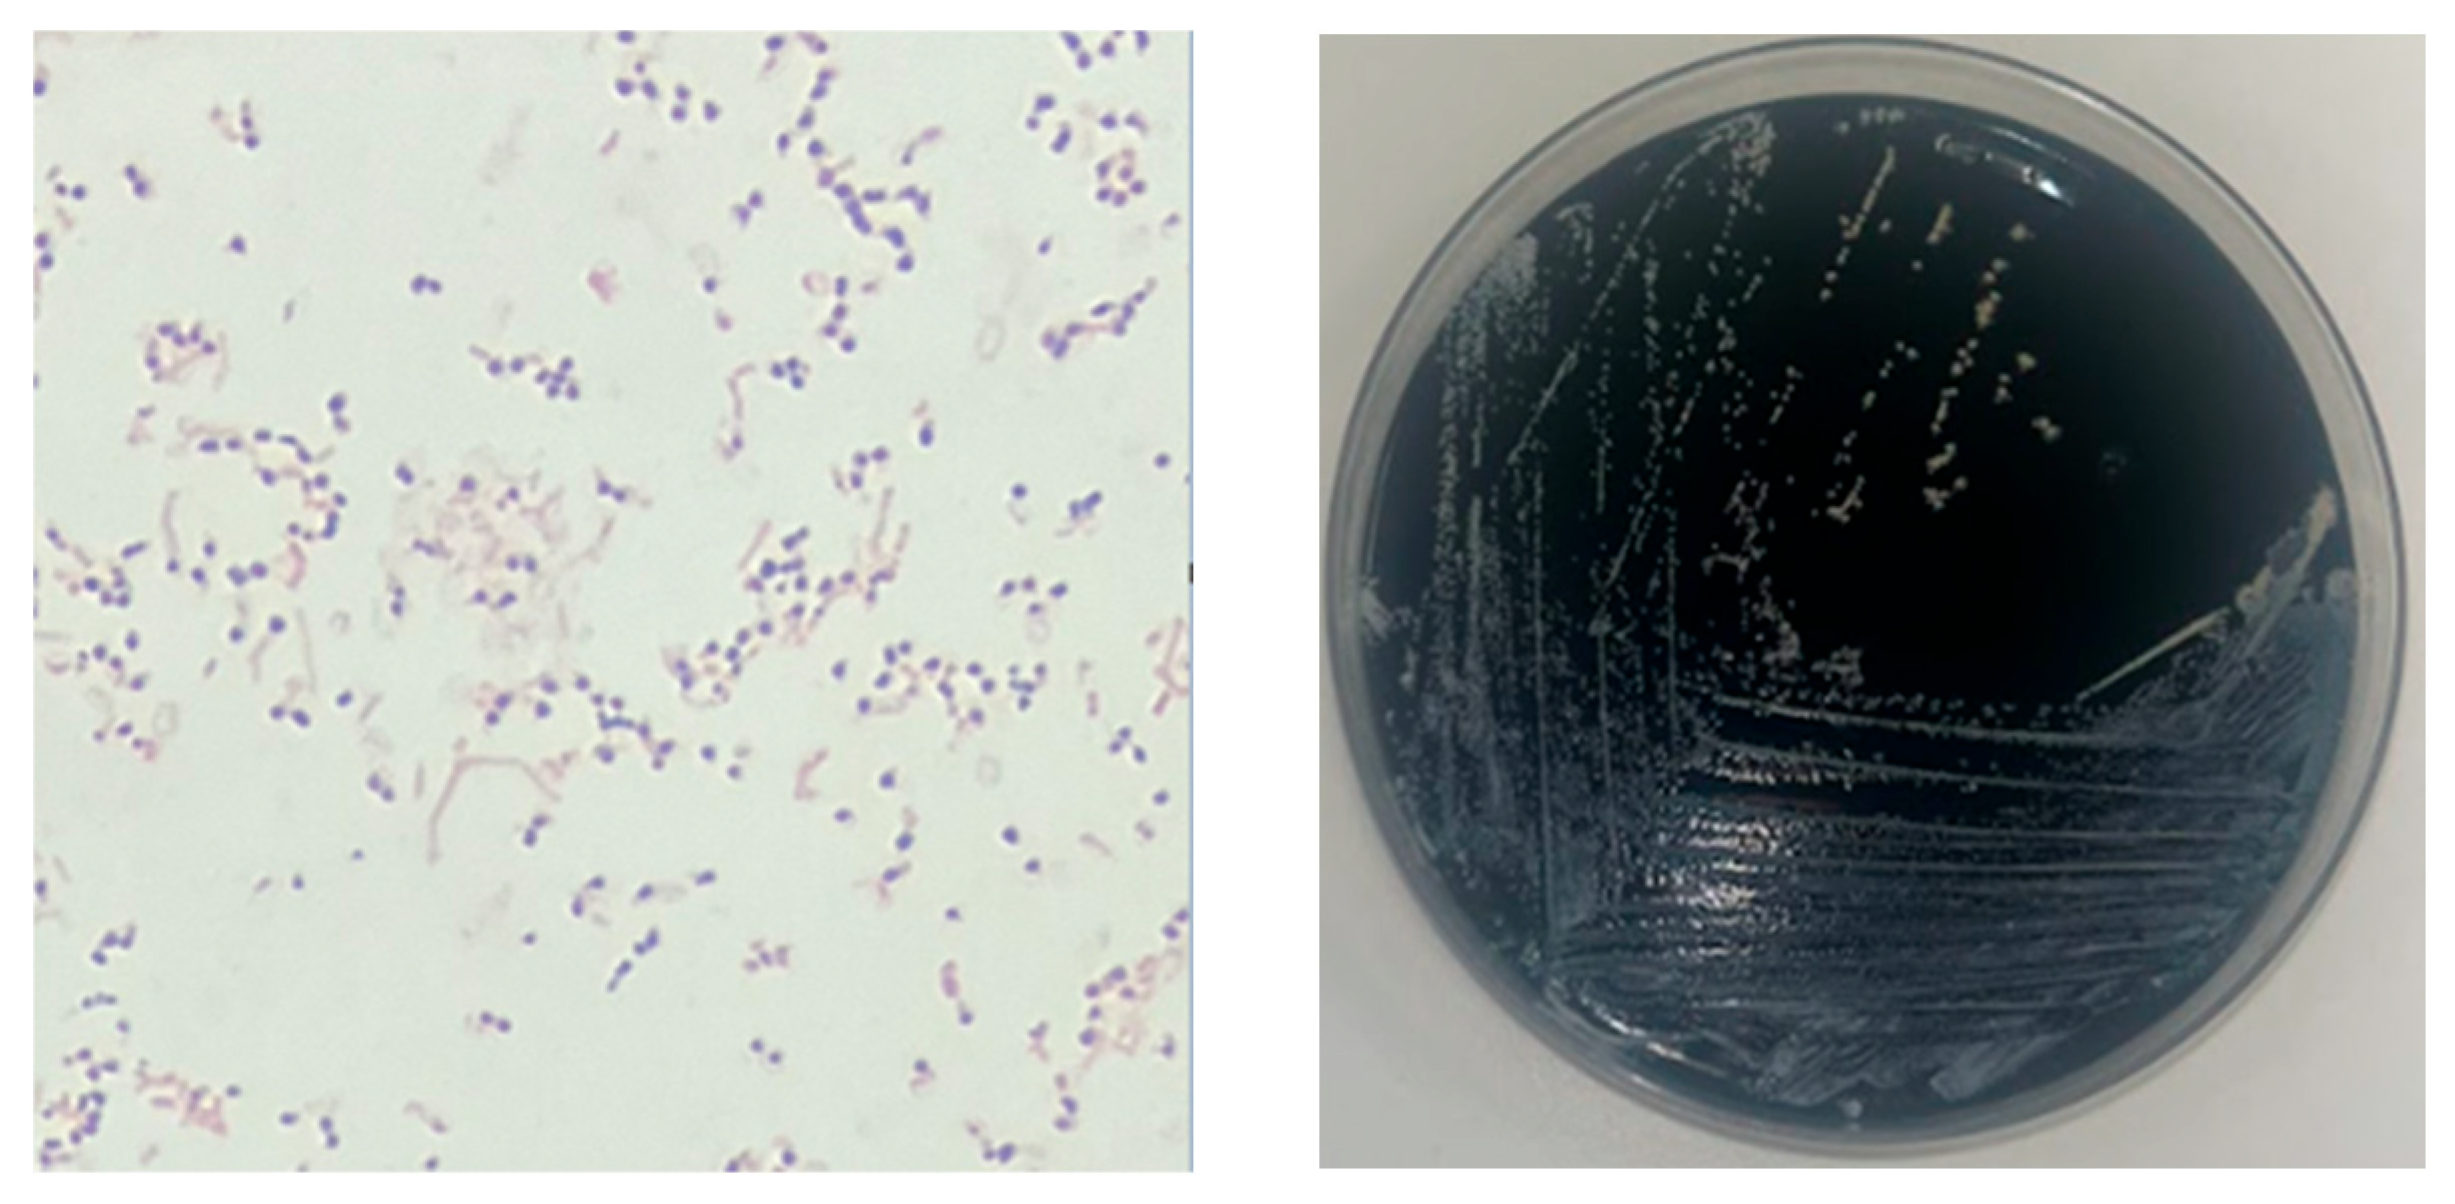
Microorganisms 13 01536 g002

Successful Treatment of Brain Abscess Caused by Nocardia farcinica with Combination Therapy Despite Discrepancies in In Vitro Results: A Case Report and Review of Diagnostic and Therapeutic Challenges
Abstract
1. Introduction
2. Case Report
3. Discussion
3.1. Microbiological Diagnosis
3.2. Treatment of CNS Nocardiosis
4. Conclusions
Author Contributions
Funding
Institutional Review Board Statement
Informed Consent Statement
Data Availability Statement
Conflicts of Interest
References
- Coussement, J.; Lebeaux, D.; Rouzaud, C.; Lortholary, O. Nocardia infections in solid organ and hematopoietic stem cell transplant recipients. Curr. Opin. Infect. Dis. 2017, 30, 545–551. [Google Scholar] [CrossRef] [PubMed]
- Soueges, S.; Bouiller, K.; Botelho-Nevers, E.; Gagneux-Brunon, A.; Chirouze, C.; Rodriguez-Nava, V.; Dumitrescu, O.; Triffault-Fillit, C.; Conrad, A.; Lebeaux, D.; et al. Prognosis and factors associated with disseminated nocardiosis: A ten-year multicenter study. J. Infect. 2022, 85, 130–136. [Google Scholar] [CrossRef] [PubMed]
- Brown-Elliott, B.A.; Brown, J.M.; Conville, P.S.; Wallace, R.J. Clinical and laboratory features of the Nocardia spp. based on current molecular taxonomy. Clin. Microbiol. Rev. 2006, 19, 259–282. [Google Scholar] [CrossRef] [PubMed]
- Coussement, J.; Lebeaux, D.; van Delden, C.; Guillot, H.; Freund, R.; Marbus, S.; Melica, G.; Van Wijngaerden, E.; Douvry, B.; European Study Group for Nocardia in Solid Organ Transplantation; et al. Nocardia Infection in Solid Organ Transplant Recipients: A Multicenter European Case-control Study. Clin. Infect. Dis. 2016, 63, 338–345. [Google Scholar] [CrossRef] [PubMed]
- Rafiei, N.; Peri, A.M.; Righi, E.; Harris, P.; Paterson, D.L. Central nervous system nocardiosis in Queensland: A report of 20 cases and review of the literature. Medicine 2016, 95, e5255. [Google Scholar] [CrossRef] [PubMed]
- Lebeaux, D.; Coussement, J.; Bodilsen, J.; Tattevin, P. Management dilemmas in Nocardia brain infection. Curr. Opin. Infect. Dis. 2021, 34, 611. [Google Scholar] [CrossRef] [PubMed]
- Averbuch, D.; De Greef, J.; Duréault, A.; Wendel, L.; Tridello, G.; Lebeaux, D.; Mikulska, M.; Gil, L.; Knelange, N.; Zuckerman, T.; et al. European Study Group for Nocardia in Hematopoietic Cell Transplantation. Nocardia Infections in Hematopoietic Cell Transplant Recipients: A Multicenter International Retrospective Study of the Infectious Diseases Working Party of the European Society for Blood and Marrow Transplantation. Clin. Infect. Dis. 2022, 75, 88–97. [Google Scholar] [PubMed]
- Conville, P.S.; Brown-Elliott, B.A.; Wallace, R.J.; Witebsky, F.G.; Koziol, D.; Hall, G.S.; Killian, S.B.; Knapp, C.C.; Warshauer, D.; Van, T.; et al. Multisite reproducibility of the broth microdilution method for susceptibility testing of Nocardia species. J. Clin. Microbiol. 2012, 50, 1270–1280. [Google Scholar] [CrossRef] [PubMed]
- Lebeaux, D.; Bergeron, E.; Berthet, J.; Djadi-Prat, J.; Mouniée, D.; Boiron, P.; Lortholary, O.; Rodriguez-Nava, V. Antibiotic susceptibility testing and species identification of Nocardia isolates: A retrospective analysis of data from a French expert laboratory, 2010–2015. Clin. Microbiol. Infect. Off. Publ. Eur. Soc. Clin. Microbiol. Infect. Dis. 2019, 25, 489–495. [Google Scholar] [CrossRef] [PubMed]
- Margalit, I.; Lebeaux, D.; Tishler, O.; Goldberg, E.; Bishara, J.; Yahav, D.; Coussement, J. How do I manage nocardiosis? Clin. Microbiol. Infect. 2021, 27, 550–558. [Google Scholar] [CrossRef] [PubMed]
- Beucler, N.; Farah, K.; Choucha, A.; Meyer, M.; Fuentes, S.; Seng, P.; Dufour, H. Nocardia farcinica cerebral abscess: A systematic review of treatment strategies. Neurochirurgie 2022, 68, 94–101. [Google Scholar] [CrossRef] [PubMed]
- Corsini Campioli, C.; Castillo Almeida, N.E.; O’Horo, J.C.; Challener, D.; Go, J.R.; DeSimone, D.C.; Sohail, M.R. Clinical Presentation, Management, and Outcomes of Patients with Brain Abscess due to Nocardia Species. Open Forum Infect. Dis. 2021, 8, ofab067. [Google Scholar] [CrossRef] [PubMed]
- Lafont, E.; Conan, P.L.; Rodriguez-Nava, V.; Lebeaux, D. Invasive Nocardiosis: Disease Presentation, Diagnosis and Treatment—Old Questions, New Answers? Infect. Drug Resist. 2020, 13, 4601–4613. [Google Scholar] [CrossRef] [PubMed]
- Conville, P.S.; Brown-Elliott, B.A.; Smith, T.; Zelazny, A.M. The Complexities of Nocardia Taxonomy and Identification. J. Clin. Microbiol. 2018, 56, e01419-17. [Google Scholar] [CrossRef] [PubMed]
- M62 CLSI; Performance Standards for Susceptibility Testing of Mycobacteria, Nocardia spp., and Other Aerobic Actinomycetes. Annapolis Junction: Howard County, MD, USA, 2018.
- Larruskain, J.; Idigoras, P.; Marimón, J.M.; Pérez-Trallero, E. Susceptibility of 186 Nocardia sp. isolates to 20 antimicrobial agents. Antimicrob. Agents Chemother. 2011, 55, 2995–2998. [Google Scholar] [CrossRef] [PubMed]
- Valdezate, S.; Garrido, N.; Carrasco, G.; Medina-Pascual, M.J.; Villalón, P.; Navarro, A.M.; Saéz-Nieto, J.A. Epidemiology and susceptibility to antimicrobial agents of the main Nocardia species in Spain. J. Antimicrob. Chemother. 2017, 72, 754–761. [Google Scholar] [PubMed]
- Glupczynski, Y.; Berhin, C.; Janssens, M.; Wauters, G. Determination of antimicrobial susceptibility patterns of Nocardia spp. from clinical specimens by Etest. Clin. Microbiol. Infect. Off. Publ. Eur. Soc. Clin. Microbiol. Infect. Dis. 2006, 12, 905–912. [Google Scholar] [CrossRef] [PubMed]
- Brown-Elliott, B.A.; Biehle, J.; Conville, P.S.; Cohen, S.; Saubolle, M.; Sussland, D.; Wengenack, N.; Kriel, K.; Bridge, L.; McNulty, S.; et al. Sulfonamide resistance in isolates of Nocardia spp. from a US multicenter survey. J. Clin. Microbiol. 2012, 50, 670–672. [Google Scholar] [CrossRef] [PubMed]

| Initial therapy | |
|---|---|
| Day 1 |
|
| Day 4 |
|
| Day 8 |
|
| Day 14 |
|
| Day 28 |
|
| Maintenance therapy | |
| Day 98 |
|
| Day 210 |
|
| Day 211 |
|
| Secondary prophylaxis | |
| Day 488 |
|
| Antibiotic | Gradient Strip Method (ULB-LHUB) | Broth Microdilution (French CNR) | ||
|---|---|---|---|---|
| MIC (μg/mL) | Interpretation | MIC (μg/mL) | Interpretation | |
| Amoxicillin-Clavulanate | 2 | S | 8 | S |
| Ceftriaxone | 8 | S | 64 | R |
| Imipenem | 0.25 | S | 4 | S |
| TMP/SMX | 0.125 | S | 1 | S |
| Amikacin | 2 | S | 1 | S |
| Moxifloxacin | <0.25 | S | <0.25 | S |
| Minocycline | - | - | 2 | I |
Disclaimer/Publisher’s Note: The statements, opinions and data contained in all publications are solely those of the individual author(s) and contributor(s) and not of MDPI and/or the editor(s). MDPI and/or the editor(s) disclaim responsibility for any injury to people or property resulting from any ideas, methods, instructions or products referred to in the content. |
© 2025 by the authors. Licensee MDPI, Basel, Switzerland. This article is an open access article distributed under the terms and conditions of the Creative Commons Attribution (CC BY) license (https://creativecommons.org/licenses/by/4.0/).
Share and Cite
Larrañaga Lapique, E.; Gallemaers, S.; Schuind, S.; Mabiglia, C.; Yin, N.; Martiny, D.; Hites, M. Successful Treatment of Brain Abscess Caused by Nocardia farcinica with Combination Therapy Despite Discrepancies in In Vitro Results: A Case Report and Review of Diagnostic and Therapeutic Challenges. Microorganisms 2025, 13, 1536. https://doi.org/10.3390/microorganisms13071536
Larrañaga Lapique E, Gallemaers S, Schuind S, Mabiglia C, Yin N, Martiny D, Hites M. Successful Treatment of Brain Abscess Caused by Nocardia farcinica with Combination Therapy Despite Discrepancies in In Vitro Results: A Case Report and Review of Diagnostic and Therapeutic Challenges. Microorganisms. 2025; 13(7):1536. https://doi.org/10.3390/microorganisms13071536
Chicago/Turabian StyleLarrañaga Lapique, Eva, Salomé Gallemaers, Sophie Schuind, Chiara Mabiglia, Nicolas Yin, Delphine Martiny, and Maya Hites. 2025. "Successful Treatment of Brain Abscess Caused by Nocardia farcinica with Combination Therapy Despite Discrepancies in In Vitro Results: A Case Report and Review of Diagnostic and Therapeutic Challenges" Microorganisms 13, no. 7: 1536. https://doi.org/10.3390/microorganisms13071536
APA StyleLarrañaga Lapique, E., Gallemaers, S., Schuind, S., Mabiglia, C., Yin, N., Martiny, D., & Hites, M. (2025). Successful Treatment of Brain Abscess Caused by Nocardia farcinica with Combination Therapy Despite Discrepancies in In Vitro Results: A Case Report and Review of Diagnostic and Therapeutic Challenges. Microorganisms, 13(7), 1536. https://doi.org/10.3390/microorganisms13071536







